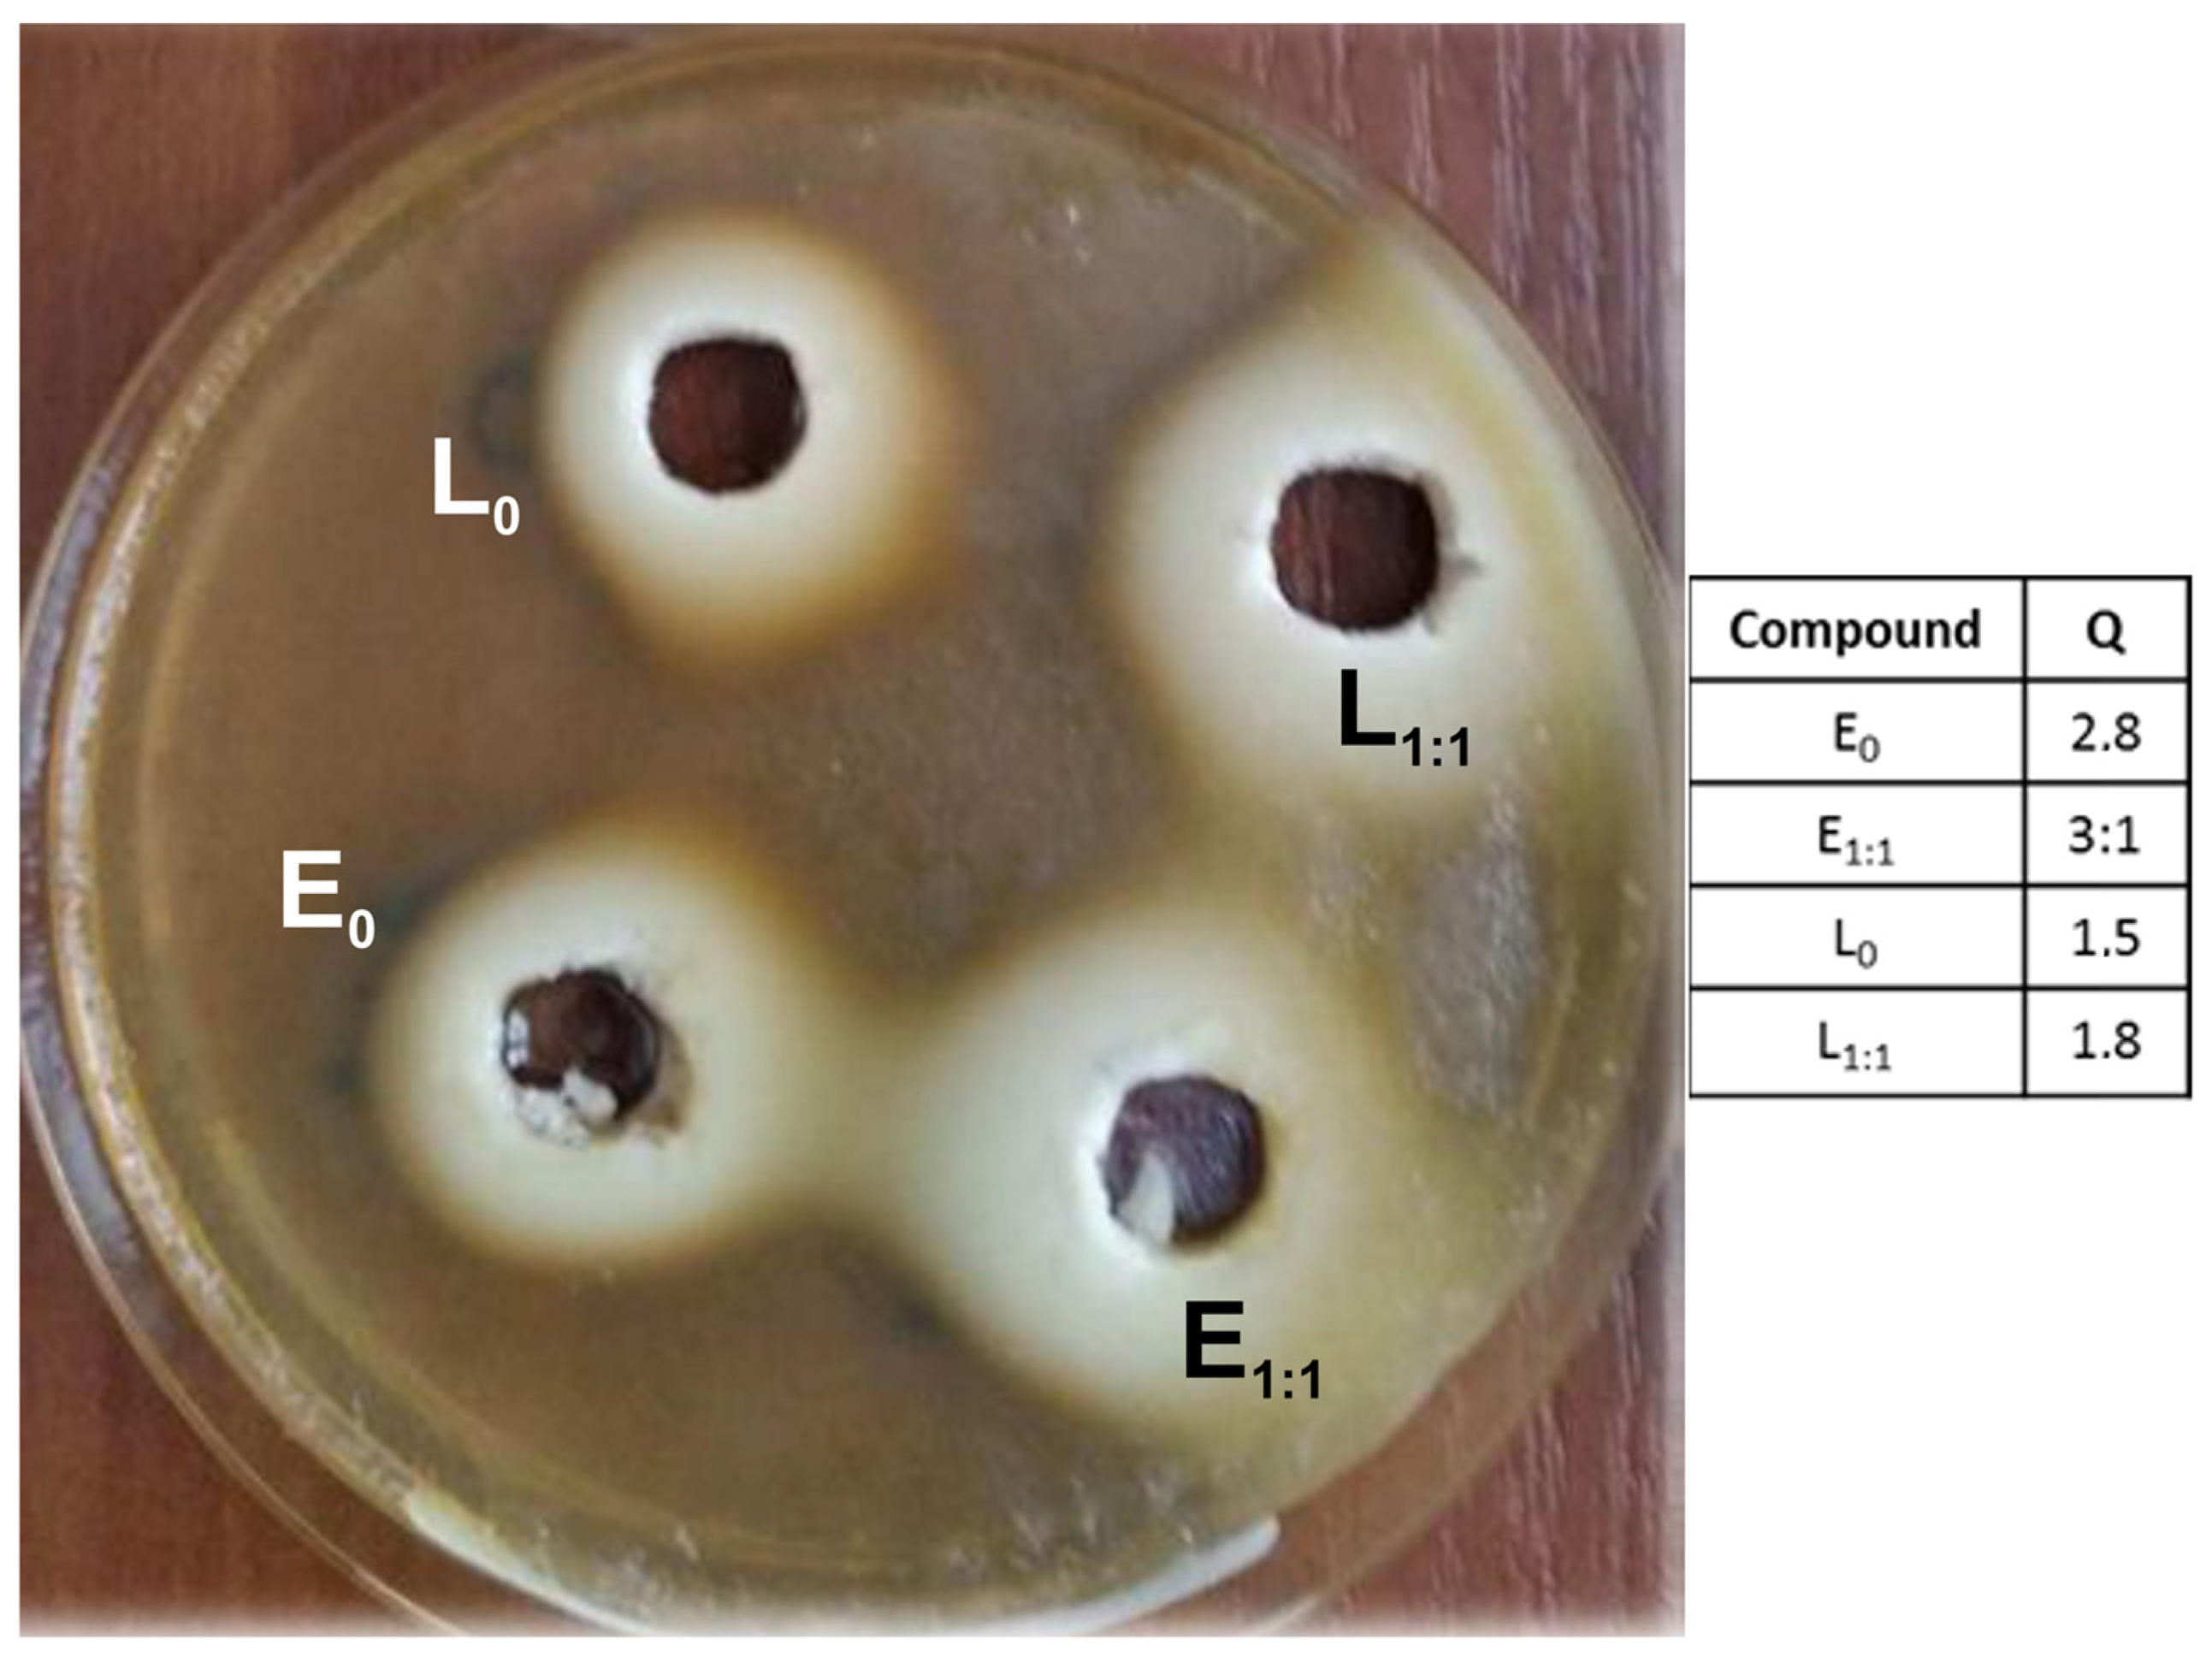
Materials 16 01381 g008

Hybrid Bio-Based Silicone Coatings with Anti-adhesive Properties
Abstract
:1. Introduction
2. Materials and Methods
2.1. Synthesis of Functionalized Polysiloxanes
- P-E-100:
- 1H NMR (CDCl3) δ (ppm): 0.12 (-CH2SiMe3); 0.23 (MeSi(O2/2)CH2- + -OSiMe3); 0.58 (-CH2SiMe3); 0.72 (MeSi(O2/2)CH2-); 1.78 (SiCH2CH2CH2-); 2.68 (SiCH2CH2CH2-); 3.87 (OCH3); 6.09 (OH); 6.79, 6.99 (Ar)
- 13C NMR (CDCl3) δ (ppm): −2.13 (-CH2SiMe3); 0.02 (MeSi(O2/2)CH2-); 2.04 (-OSiMe3); 17.56 (MeSi(O2/2)CH2-); 25.52 (SiCH2CH2CH2-); 40.00 (SiCH2CH2CH2-); 55.85 (OCH3); 111.36, 114.57, 121.06, 130.75, 134.52, 143.75, 146.61 (Ar)
- 29Si NMR (CDCl3) δ (ppm): −22.52 (E-MeSi(O2/2)CH2-); 3.22 (-CH2SiMe3); 7.38 (-OSiMe3)
- P-E-50:
- 1H NMR (CDCl3) δ (ppm): 0.125 (-CH2SiMe3); 0.23 (MeSi(O2/2)CH2- + -OSiMe3); 0.58 (-CH2SiMe3); 0.72 (MeSi(O2/2)CH2-); 1.78 (SiCH2CH2CH2-); 2.68 (SiCH2CH2CH2-); 4.02 (OCH3); 5.65 (OH); 6.79, 6.99 (Ar)
- 13C NMR (CDCl3) δ (ppm): −2.13 (-CH2SiMe3); −0.09 MeSi(O2/2)CH2-); 1.36 (Me2Si(O2/2); 2.02 (-OSiMe3); 17.46 (MeSi(O2/2)CH2-); 25.55 (SiCH2CH2CH2-); 39.36 (SiCH2CH2CH2-); 55.85 (OCH3); 111.30, 114.61, 121.12, 134.55, 143.84, 146.63 (Ar)
- 29Si NMR (CDCl3) δ (ppm): −22.29 (E-MeSi(O2/2)CH2-); −21.80 (Me2Si(O2/2)CH2-); 3.20 (-CH2SiMe3); 7.43 -(OSiMe3)
- P-L-100:
- 1H NMR (CDCl3) δ (ppm): −0.01 (-CH2SiMe3); 0.10 (MeSi(O2/2)CH2- + -OSiMe3); 0.55 (MeSi(O2/2)CH2-); 1.15 (MeSi(O2/2)CH2CH2C(OH)CH3-); 1.49 ((MeSi(O2/2)CH2CH2C(OH)CH3-); 1.6–1.8 (-C(OH)(CH3) CH2CH2CH = C(CH3)2); 2.03 (-C(OH)(CH3)CH2CH2CH = C(CH3)2); 5.13 (-CH=)
- 13C NMR (CDCl3) δ (ppm): −2.27 (-CH2SiMe3); −0.25 (MeSi(O2/2)CH2); 2.02 (-OSiMe3); 11.23 (MeSi(O2/2)CH2-); 17.68 (=CCH3), 22.66 (-C(OH)(CH3)CH2CH2CH=); 25.65 (-C(OH)(CH3)CH2CH2CH=); 25.82 (=CCH3); 35.22 (-SiCH2CH2C(OH)(CH3)-); 41.13 ((-C(OH)(CH3)2CH2CH2CH=); 72.92 (SiCH2CH2C(OH)(CH3)-); 124.57 (-CH=); 131.07 (=C(CH2)
- 29Si NMR (CDCl3) δ (ppm): −21.51 (L-MeSi(O2/2)CH2-); 3.13 (-CH2SiMe3); 7.54 -(OSiMe3)
- P-L-50
- 1H NMR (CDCl3) δ (ppm): −0.01 (-CH2SiMe3); 0.10 (MeSi(O2/2)CH2- + -OSiMe3); 0.55 (MeSi(O2/2)CH2-); 1.16 (MeSi(O2/2)CH2CH2C(OH)CH3-); 1.47 ((MeSi(O2/2)CH2CH2C(OH)CH3-); 1.62 (-C(OH)(CH3)2CH2CH2CH=C(CH3)2; 1.69 (-C(OH)(CH3)2CH2CH2CH=C(CH3)2); 2.03 (-C(OH)(CH3)2CH2CH2CH=C(CH3)2); 5.13 (-CH=)
- 13C NMR (CDCl3) δ (ppm): −2.27 (-CH2SiMe3); −0.54 (MeSi(O2/2)CH2); 1.13 (Me2Si(O2/2)-); 1.77 -OSiMe3); 11.13 (MeSi(O2/2)CH2-); 17.68 (=CCH3); 22.66 (-C(OH)(CH3)2CH2CH2CH=); 25.57 (-C(OH)(CH3)CH2CH2CH=); 26.02 (=CCH3); 34.82 (-SiCH2CH2C(OH)(CH3)-); 40.93 (-C(OH)(CH3)2CH2CH2CH=); 72.95 (SiCH2CH2C(OH)(CH3)-); 124.57 (-CH=); 131.07 (=C(CH2)
- 29Si NMR (CDCl3) δ (ppm): −22.03 (L-MeSi(O2/2)CH2-; Me2Si(O2/2)CH2-); 2.92 (-CH2SiMe3); 7.18 -(OSiMe3)
2.2. Synthesis of Functionalized Triethoxysilanes
- E-Si(OEt)3
- 1H NMR (CDCl3) δ (ppm): 0.69 (-SiCH2-); 1.24 (-OCH2CH3); 1.73 (-SiCH2CH2CH2-Ar); 2.59 (-CH2-Ar); 3.84 (-OCH2CH3); 5.64 (-OCH3); 6.69, 6.84 (Ar)
- 13C NMR (CDCl3) δ (ppm): 9.89 (-SiCH2-); 17.88 (-OCH2CH3); 25.03 (-SiCH2CH2CH2-Ar); 38.63 (CH2-Ar); 55.27 (OCH3); 58.12 (-OCH2CH3); 111.11, 114.45, 120.83, 133.85, 143.94, 146.63 (Ar)
- 29Si NMR (CDCl3) δ (ppm): −44.89
- L-Si(OEt)3
- 1H NMR (CDCl3) δ (ppm): 0.75 (-SiCH2); 1.47 (-SiCH2CH2C(OH)(CH3)-) + (-OCH2CH3); 1.52 (-SiCH2CH2-); 1.6–1.8 (-C(OH)(CH3)CH2CH2CH=C(CH3)2); 2.07 (-C(OH)(CH3)CH2CH2CH=); 3.86 (-OCH2CH3); 5.13 (-CH=)
- 13C NMR (CDCl3) δ (ppm): 4.16 (-SiCH2-); 17.99 (-OCH2CH3 + =CCH3); 22.72 (C(OH)(CH3)CH2CH2CH=C(CH3)2); 25.42 (=CCH3); 26.94 ((-SiCH2CH2C(OH)(CH3)-); 35.59 (-SiCH2CH2-); 42.54 (-C(OH)(CH3)CH2CH2CH=C(CH3)2); 58.87 (-OCH2CH3); 72.32 (-SiCH2CH2C(OH)(CH3)-); 124.34 (-CH=); 130.89 (=C(CH2)2)
- 29Si NMR (CDCl3) δ (ppm): −28.03 (42%, L-Si(OEt)3); −35.11 (43%, L-Si(OEt)2(OSi-)); −43.49 (15%, L-Si(OEt)(OSi-)2)
2.3. Preparation of Hybrid Silsesquioxane Sols and Coatings
2.4. Analytic Methods
2.4.1. Nuclear Magnetic Resonance Spectroscopy (NMR)
2.4.2. Fourier Transform Infrared Spectroscopy (FT-IR)
2.4.3. Thermogravimetric Analysis (TGA)
2.4.4. Differential Scanning Calorimetry (DSC)
2.4.5. Surface Energy Measurements
2.4.6. Raman Mapping
2.4.7. Molecular Modelling
2.5. Biological Studies
2.5.1. Bacterial Strain
2.5.2. Assessment of Bacterial Adhesion
2.5.3. Determination of Antimicrobial Activity of Compounds Used to Create Functional Polymers
2.5.4. Statistical Methods
3. Results and Discussion
3.1. Synthesis and Properties of Organosilicon Derivatives of Eugenol and Linalool
3.1.1. Functionalized Polysiloxanes and Oligomeric Silsesquioxanes
3.1.2. Thermal Properties of Polysiloxanes Grafted with Eugenol and Linalool
3.2. Surface Structure and Properties of Thin Films Obtained with Functionalized Polysiloxanes and Hybrid Silsesquioxane Sols
3.2.1. Coatings Made of Functionalized Silsesquioxane Sols
3.2.2. Contact-Angle Measurements
3.3. Antibiofilm Properties of the Functionalized Silicones
3.3.1. Antimicrobial Activity of Compounds Used in the Synthesis of Functional Polymers
3.3.2. Anti-adhesive Properties of the Functionalized Silicones
4. Conclusions
Supplementary Materials
Author Contributions
Funding
Institutional Review Board Statement
Informed Consent Statement
Data Availability Statement
Acknowledgments
Conflicts of Interest
Sample Availability
References
- Jones, R.G.; Ando, W.; Chojnowski, J. (Eds.) Silicon-Containing Polymers. In The Science and Technology of Their Synthesis and Applications; Springer Science+Business Media: Berlin, Germany, 2000; Section 1; pp. 1–244. [Google Scholar]
- Abe, Y.; Gunji, T. Oligo- and polysiloxanes. Progr. Polym. Sci. 2004, 29, 149–182. [Google Scholar] [CrossRef]
- Curtis, J.; Colas, A. Chapter II. 5.18—Medical applications of silicones A2—Ratner, Buddy, D. In Biomaterials Science, 3rd ed.; Hoffman, A.S., Schoen, F.J., Lemons, J.E., Eds.; Academic Press: Cambridge, MA, USA, 2013; pp. 1106–1116. ISBN 9780080877808. [Google Scholar]
- Mojsiewicz-Pieńkowska, K. Safety and Toxicity Aspects of Polysiloxanes (Silicones) Applications. In Chapter 16 in Concise Encylopedia of High Performance Silicones; Tiwari, A., Soucek, M.D., Eds.; Scrivener Publishing LLC.: Beverly, MA, USA, 2014; pp. 243–252. ISBN 9781118938478. [Google Scholar]
- Owen, M.J. Silicone hydrophobicity and oleophilicity. Silicon 2014, 9, 651–655. [Google Scholar] [CrossRef]
- Chen, A.; Peng, H.; Blakey, I.; Whittaker, A.K. Biocidal Polymers: A Mechanistic Overview. Polym. Rev. 2007, 57, 276–310. [Google Scholar] [CrossRef]
- Muñoz-Bonilla, A.; Fernandez-Garcia, M. Polymeric materials with antimicrobial activity. Progr. Polym. Sci. 2012, 37, 281–339. [Google Scholar] [CrossRef]
- Kottmann, A.; Mejίa, E.; Hémery, T.; Klein, J.; Kragl, U. Recent Developments in the Preparation of Silicones with Antimicrobial Properties. Chem. Asian J. 2017, 12, 1168–1179. [Google Scholar] [CrossRef] [PubMed]
- Krishnan, S.; Weinman, C.J.; Ober, C.K. Advances in polymers for anti-biofouling surfaces. J. Mater. Chem. 2008, 18, 3405–3413. [Google Scholar] [CrossRef]
- Ganewatta, M.S.; Chuanbing Tang, C. Controlling macromolecular structures towards effective antimicrobial polymers. Polymer 2015, 63, A1–A29. [Google Scholar] [CrossRef]
- Yuan, Y.; Hays, M.P.; Hardwidge, P.R.; Kim, J. Surface characteristics influencing bacterial adhesion to polymeric substrates. RSC Adv. 2017, 7, 14254–14261. [Google Scholar] [CrossRef]
- Lam, M.; Migonney, V.; Falentin-Daudre, C. Review of silicone surface modification techniques and coatings for antibacterial/antimicrobial applications to improve breast implant surfaces. Acta Biomater. 2021, 119, 42–56. [Google Scholar] [CrossRef]
- Jiao, Y.; Niu, L.; Ma, S.; Li, J.; Tay, F.R.; Chen, J. Quaternary ammonium-based biomedical materials: State-of-the-art, toxicological aspects and antimicrobial resistance. Progr. Polym. Sci. 2017, 71, 53–90. [Google Scholar] [CrossRef]
- Bapat, R.A.; Parolia, A.; Chaubal, T.; Yang, H.J.; Kesharwani, P.; Phaik, K.S.; Lin, S.L.; Daood, U.; Matinlinna, J.P.; Pichika, M.R.; et al. A quaternary ammonium silane antimicrobial triggers bacterial membrane and biofilm destruction. Sci. Rep. 2020, 10, 10970. [Google Scholar] [CrossRef]
- Daood, U. Recent Update on Ap-plications of Quaternary Ammonium Silane as an Antibacterial Biomaterial: A Novel Drug Delivery Approach in Dentistry. Front. Microbiol. 2022, 1323, 927282. [Google Scholar] [CrossRef]
- Park, S.; Kim, J.-Y.; Choi, W.; Lee, M.-J.; Heo, J.; Choi, D.; Jung, S.; Kwon, J.; Choi, S.-H.; Hong, J. Ladder-like polysilsesquioxanes with antibacterial chains and durable siloxane networks. Chem. Eng. J. 2020, 3931, 124686. [Google Scholar] [CrossRef]
- Park, S.; Jeong, H.-J.; Moon, J.-H.; Jang, E.-Y.; Jung, S.; Choi, M.; Choi, W.; Park, K.; Ahn, H.-W.; Hong, J. Polysilsesquioxane with potent resistance to intraoral stress: Functional coating material for the advanced dental materials. Appl. Surf. Sci. 2022, 57815, 152085. [Google Scholar] [CrossRef]
- Gharibi, R.; Yeganeh, H.; Kazemi, S. Green and non-leaching anti-bacterial and cytocompatible coating with build-in quaternary ammonium salt derived from methoxysilane functionalized soybean oil. Mater. Sci. Eng. C 2019, 99, 887–899. [Google Scholar] [CrossRef]
- Aslanidou, D.; Karapanagiotis, I. Superhydrophobic, superoleophobic and antimicrobial coatings for the protection of silk textiles. Coatings 2018, 8, 101. [Google Scholar] [CrossRef]
- Hawkins, M.L.; Faÿ, F.; Réhel, K.; Linossier, I.; Grunlan, M.A. Bacteria and diatom resistance of silicones modified with PEO-silane amphiphiles. Biofouling 2014, 30, 247–258. [Google Scholar] [CrossRef]
- Hawkins, M.L.; Schott, S.S.; Grigoryan, B.; Rufin, M.A.; Ngo, B.K.D.; Vanderwal, L.; Stafslien, S.J.; Grunlan, M.A. Anti-protein and anti-bacterial behavior of amphiphilic silicones. Polym. Chem. 2017, 8, 5239–5251. [Google Scholar] [CrossRef]
- Kuliasha, C.A.; Finlay, J.A.; Franco, S.C.; Clare, A.S.; Stafslien, S.J.; Brennan, A.B. Marine anti-biofouling efficacy of amphiphilic poly(coacrylate) grafted PDMSe: Effect of graft molecular weight. Biofouling 2017, 33, 252–267. [Google Scholar] [CrossRef]
- Guazzelli, E.; Galli, G.; Martinelli, E.; Margaillan, A.; Bressy, C. Amphiphilic hydrolyzable polydimethylsiloxane-b-poly(ethyleneglycol methacrylate-co-trialkylsilyl methacrylate) block copolymers for marine coatings. I. Synthesis, hydrolysis and surface wettability. Polymer 2020, 186, 121954. [Google Scholar] [CrossRef]
- Campoccia, D.; Montanaro, L.; Arciola, C.R. A review of the biomaterials technologies for infection-resistant surfaces. Biomaterials 2013, 34, 8533–8554. [Google Scholar] [CrossRef] [PubMed]
- Nowacka, M.; Rygała, A.; Kręgiel, D.; Kowalewska, A. Poly(silsesquioxanes) and poly(siloxanes) grafted with N-acetylcysteine for eradicating mature bacterial biofilms in water environment. Colloids Surf. B Biointerfaces 2018, 172, 627–634. [Google Scholar] [CrossRef] [PubMed]
- Kim, Y.D.; Dordick, J.S.; Clark, D.S. Siloxane-Based Biocatalytic Films and Paints for Use as Reactive Coatings. Biotechnol. Bioeng. 2001, 72, 475–482. [Google Scholar] [CrossRef] [PubMed]
- Kregiel, D.; Rygala, A.; Kolesinska, B.; Nowacka, M.; Herc, A.S.; Kowalewska, A. Antimicrobial and antibiofilm n-acetyl-l-cysteine grafted siloxane polymers with potential for use in water systems. Int. J. Mol. Sci. 2019, 20, 2011. [Google Scholar] [CrossRef]
- Drozdov, F.V.; Tarasenkov, A.N.; Parshina, M.S.; Cherkaev, G.V.; Strukova, E.N.; Muzafarov, A.M. Synthesis of guanidinopropyl triethoxysilane and its homopolymer as a new class of organosilicon antibacterial agents. J. Organomet. Chem. 2020, 918, 121243. [Google Scholar] [CrossRef]
- Nowacka, M.; Rygała, A.; Kręgiel, D.; Kowalewska, A. New antiadhesive hydrophobic polysiloxanes. Molecules 2021, 26, 814. [Google Scholar] [CrossRef]
- Cozma, V.; Rosca, I.; Radulescu, L.; Martu, C.; Nastasa, V.; Varganici, C.-D.; Ursu, E.-L.; Doroftei, F.; Pinteala, M.; Racles, C. Antibacterial Polysiloxane Polymers and Coatings for Cochlear Implants. Molecules 2021, 26, 4892. [Google Scholar] [CrossRef] [PubMed]
- Shariati, A.; Didehdar, M.; Razavi, S.; Heidary, M.; Soroush, F.; Chegini, Z. Natural Compounds: A Hopeful Promise as an Antibiofilm Agent Against Candida Species. Front. Pharmacol. 2022, 13, 917787. [Google Scholar] [CrossRef]
- Alrahlah, A.; Al-Odayni, A.-B.; Saeed, W.S.; Al-Kahtani, A.; Alkhtani, F.M.; Al-Maflehi, N.S. Water Sorption, Water Solubility, and Rheological Properties of Resin-Based Dental Composites Incorporating Immobilizable Eugenol-Derivative Monomer. Polymers 2022, 14, 366. [Google Scholar] [CrossRef]
- Marchese, A.; Barbieri, R.; Coppo, E.; Orhan, I.E.; Daglia, M.; Nabavi, S.F.; Izadi, M.; Abdollahi, M.; Nabavi, S.M.; Ajami, M. Antimicrobial activity of eugenol and essential oils containing eugenol: A mechanistic viewpoint. Crit. Rev. Microbiol. 2017, 43, 668–689. [Google Scholar] [CrossRef]
- Modjinou, T.; Versace, D.-L.; Abbad-Andallousi, S.; Bousserrhine, N.; Dubot, P.; Langlois, V.; Renard, E. Antibacterial and antioxidant bio-based networks derived from eugenol using photo-activated thiol-ene reaction. React. Funct. Polym. 2016, 101, 47–53. [Google Scholar] [CrossRef]
- Li, C.-H.; Chen, X.; Landis, R.F.; Geng, Y.; Makabenta, J.M.; Lemnios, W.; Gupta, A.; Rotello, V.M. Phytochemical-Based Nanocomposites for the Treatment of Bacterial Biofilms. ACS Infect. Dis. 2019, 5, 1590–1596. [Google Scholar] [CrossRef] [PubMed]
- Arévalo, S.; Benito, J.M.; de Jesús, E.; de la Mata, F.J.; Flores, J.C.; Gómez, R. Silane dendrimers containing titanium complexes on their periphery. J. Organomet. Chem. 2000, 602, 208–210. [Google Scholar] [CrossRef]
- Chen, G.; Feng, J.; Qiu, W.; Zhao, Y. Eugenol-modified polysiloxanes as effective anticorrosion additives for epoxy resin coatings. RSC Adv. 2017, 7, 55967–55976. [Google Scholar] [CrossRef]
- Walczak, M.; Franczyk, A.; Dutkiewicz, M.; Marciniec, B. Synthesis of Bifunctional Silsesquioxanes (RSiMe2O)∼4(R′SiMe2O)∼4Si8O12 via Hydrosilylation of Alkenes. Organometallics 2019, 38, 3018–3024. [Google Scholar] [CrossRef]
- Ji, J.; Ge, X.; Liang, W.; Liang, R.; Pang, X.; Liu, R.; Wen, S.; Sun, J.; Chen, X.; Ge, J. A Simple Preparation Route for Bio-Phenol MQ Silicone Resin via the Hydrosilylation Method and its Autonomic Antibacterial Property. Polymers 2019, 11, 1389. [Google Scholar] [CrossRef]
- Yi, M.; Chen, X.; Shuttleworth, P.S.; Tan, L.; Ruan, Y.; Xu, Y.; Zheng, J.; Wu, S.; Hu, S.; Xie, S.; et al. Facile fabrication of eugenol-containing polysiloxane films with good optical properties and excellent thermal stability via Si–H chemistry. J. Mater. Chem. C 2021, 9, 8020–8028. [Google Scholar] [CrossRef]
- Sokolnicki, T.; Franczyk, A.; Janowski, B.; Walkowiak, J. Synthesis of Bio-Based Silane Coupling Agents by the Modification of Eugenol. Adv. Synth. Catal. 2021, 363, 5493–5500. [Google Scholar] [CrossRef]
- Zhang, X.; Cai, Y.; Zhang, X.; Aziz, T.; Fan, H.; Bittencourt, C. Synthesis and characterization of eugenol-based silicone modified waterborne polyurethane with excellent properties. J. Appl. Polym. Sci. 2021, 138, 50515. [Google Scholar] [CrossRef]
- Walczak, M.; Januszewski, R.; Franczyk, A.; Marcieniec, B. Synthesis of monofunctionalized POSS through hydrosilylation. J. Organomet. Chem. 2018, 872, 73–78. [Google Scholar] [CrossRef]
- Bandeira Junior, G.; Sutili, F.J.; Gressler, L.T.; Ely, V.L.; Silveira, B.P.; Tasca, C.; Reghelin, M.; Matter, L.B.; Vargas, A.P.C.; Baldisserotto, B. Antibacterial potential of phytochemicals alone or in combination with antimicrobials against fish pathogenic bacteria. J. Appl. Microbiol. 2018, 125, 655–665. [Google Scholar] [CrossRef]
- Luis, A.I.S.; Campos, E.V.R.; De Oliveira, J.L.; Guilger-Casagrande, M.; De Lima, R.; Castanha, R.F.; De Castro, V.L.S.S.; Fraceto, L.F. Zein Nanoparticles Impregnated with Eugenol and Garlic Essential Oils for Treating Fish Pathogens. ACS Omega 2020, 5, 15557–1556630. [Google Scholar] [CrossRef] [PubMed]
- Zhong, W.; Tang, P.; Liu, T.; Zhao, T.; Guo, J.; Gao, Z. Linalool nanoemulsion preparation, characterization and antimicrobial activity against Aeromonas hydrophila. Int. J. Mol. Sci. 2021, 22, 11003. [Google Scholar] [CrossRef] [PubMed]
- Drebezghova, V.; Hakil, F.; Grimaud, R.; Gojzewski, H.; Vancso, G.J.; Nardin, C. Initial bacterial retention on polydimethylsiloxane of various stiffnesses: The relevance of modulus (mis)match. Colloids Surf. B: Biointerfaces 2022, 217, 112709. [Google Scholar] [CrossRef]
- Armarego, W.L.F.; Chai, C.L.L. Purification of Laboratory Chemicals, 5th ed.; Elsevier Science: Great Britain, UK, 2003. [Google Scholar]
- Kowalewska, A.; Fortuniak, W.; Rózga-Wijas, K.; Handke, B. Thermolysis of new hybrid silsesquioxane–carbosilane materials. Thermochim. Acta 2009, 494, 45–53. [Google Scholar] [CrossRef]
- Chowdhry, B.Z.; Ryall, J.P.; Dines, T.J.; Mendham, A.P. Infrared and Raman Spectroscopy of Eugenol, Isoeugenol, and Methyl Eugenol: Conformational Analysis and Vibrational Assignments from Density Functional Theory Calculations of the Anharmonic Fundamentals. J. Phys. Chem. A 2015, 119, 11280–11292. [Google Scholar] [CrossRef] [PubMed]
- Menezes, P.P.; Serafini, M.R.; Quintans-Júnior, L.J.; Silva, G.F.; Oliveira, J.F.; Carvalho, F.M.S.; Souza, J.C.C.; Matos, J.R.; Alves, P.B.; Matos, I.L.; et al. Inclusion complex of (−)-linalool and β-cyclodextrin. J. Therm. Anal. Calorim. 2014, 115, 2429–2437. [Google Scholar] [CrossRef]
- Rodenak-Kladniew, B.; Islan, G.A.; de Bravo, M.G.; Durán, N.; Castro, G.R. Design, characterization and in vitro evaluation of linalool-loaded solid lipid nanoparticles as potent tool in cancer therapy. Colloids Surf. B Biointerfaces 2017, 154, 123–132. [Google Scholar] [CrossRef]
- Kowalewska, A.; Herc, A.S.; Bojda, J.; Palusiak, M.; Markiewicz, E.; Ławniczak, P.; Nowacka, M.; Sołtysiak, J.; Różański, A.; Piórkowska, E. Supramolecular interactions involving fluoroaryl groups in hybrid blends of laddder polysilsesquioxanes and polylactide. Polym. Test. 2021, 94, 107033. [Google Scholar] [CrossRef]
- Owens, D.K.; Wendt, R.C. Estimation of the surface free energy of polymers. J. Appl. Polym. Sci. 1969, 13, 1741–1747. [Google Scholar] [CrossRef]
- HyperChem (TM) Professional 7.51; Hypercube, Inc., 1115 NW 4th Street: Gainesville, FL, USA.
- Rygala, A.; Berlowska, J.; Kregiel, D. Heterotrophic plate count for bottled water safety management. Processes 2020, 8, 739. [Google Scholar] [CrossRef]
- Balouiri, M.; Sadiki, M.; Ibnsouda, S.K. Methods for in vitro evaluating antimicrobial activity: A review. J. Pharm. Anal. 2016, 6, 71–79. [Google Scholar] [CrossRef] [PubMed]
- Kowalewska, A.; Delczyk, B.; Chruściel, J. Chain mobility in bulky carbosilane modified polymeric siloxane systems. e-Polymers 2009, 9, 145–154. [Google Scholar] [CrossRef]
- Thomas, T.H.; Kendrick, T.C. Thermal analysis of polydimethylsiloxanes. I. Thermal degradation in controlled atmospheres. J. Polym. Sci. Part A2 Polym. Phys. 1969, 7, 537–549. [Google Scholar] [CrossRef]
- Camino, G.; Lomakin, S.M.; Lageard, M. Thermal polydimethylsiloxane degradation. Part 2. The degradation mechanisms. Polymer 2002, 43, 2011–2015. [Google Scholar] [CrossRef]
- Zhang, C.; Qu, L.; Wang, Y.; Xu, T.; Zhang, C. Thermal insulation and stability of polysiloxane foams containing hydroxyl-terminated polydimethylsiloxanes. RSC Adv. 2018, 8, 9901–9909. [Google Scholar] [CrossRef] [PubMed]
- Kowalewska, A.; Kaźmierski, S.; Delczyk-Olejniczak, B. Polymer Chain Relaxation Mechanisms in Siloxane-Carbosilane Systems. Silicon 2011, 3, 37–44. [Google Scholar] [CrossRef]
- Brinker, C.J. Hydrolysis and condensation of silicates: Effects on structure. J. Non-Cryst. Solids 1988, 100, 31–50. [Google Scholar] [CrossRef]
- Schubert, U.; Hüsing, N. Synthesis of Inorganic Materials, Chapter 1, Chemistry and Fundamentals of the Sol–Gel Process, 3rd ed.; Levy, D., Zayat, M., Eds.; VCH-Wiley Verlag GmbH: Weinheim, Germany, 2012; ISBN 3-527-32714-1. [Google Scholar] [CrossRef]
- Kowalewska, A.; Nowacka, M.; Makowski, T. Macroporous materials by self-assembly of linear oligo(phenylsilsesquioxanes). Express Polym. Lett. 2015, 9, 984–1000. [Google Scholar] [CrossRef]
- Lafhal, S.; Vanloot, P.; Bombarda, I.; Valls, R.; Kister, J.; Dupuy, N. Raman spectroscopy for identification and quantification analysis of essential oil varieties: A multivariate approach applied to lavender and lavandin essential oils. J. Raman Sepctrosc. 2015, 46, 577–585. [Google Scholar] [CrossRef]
- Jentzsch, P.V.; Gualpa, F.; Ramos, L.A.; Ciobotă, V. Adulteration of clove essential oil: Detection using a handheld Raman spectrometer. Flavour Fragr. J. 2018, 33, 184–190. [Google Scholar] [CrossRef]
- Baatti, A.; Erchiqui, F.; Bébin, P.; Godard, F.; Bussières, D. A two-step Sol-Gel method to synthesize a ladder polymethylsilsesquioxane nanoparticles. Adv. Powder Technol. 2017, 28, 1038–1046. [Google Scholar] [CrossRef]
- Park, S.C.; Nam, J.P.; Kim, J.H.; Kim, Y.M.; Nah, J.W.; Jang, M.K. Antimicrobial action of water-soluble β-chitosan against clinical multi-drug resistant bacteria. Int. J. Mol. Sci. 2015, 16, 7995–8007. [Google Scholar] [CrossRef] [PubMed]
- Lahiri, D.; Nag, M.; Dutta, B.; Dey, S.; Mukherjee, D.; Joshi, S.J.; Ray, R.R. Antibiofilm and anti-quorum sensing activities of eugenol and linalool from Ocimum tenuiflorum against Pseudomonas aeruginosa biofilm. J. Appl. Microbiol. 2021, 131, 2821–2837. [Google Scholar] [CrossRef] [PubMed]
- Fraňková, A.; Marounek, M.; Mozrová, V.; Weber, J.; Klouček, P.; Lukešová, D. Antibacterial activities of plant-derived compounds and essential oils toward Cronobacter sakazakii and Cronobacter malonaticus. Foodborne Pathog. Dis. 2014, 11, 795–797. [Google Scholar] [CrossRef]
- An, Q.; Ren, J.N.; Li, X.; Fan, G.; Qu, S.S.; Song, Y.; Li, Y.; Pan, S.Y. Recent updates on bioactive properties of linalool. Food Funct. 2021, 12, 10370–10389. [Google Scholar] [CrossRef]
- Taleuzzaman, M.; Jain, P.; Verma, R.; Iqbal, Z.; Mirza, M.A. Eugenol as a Potential Drug Candidate: A Review. Curr. Top. Med. Chem. 2021, 21, 1804–1815. [Google Scholar] [CrossRef]

| Sample | Residue [%] | Residue Calculated for SiO2 [%] | Td5% [oC] | Td1 [oC] |
|---|---|---|---|---|
| P-H-100 | 11.1 | 0.0 | 159.3 | 276.3 |
| P-H-50 | 1.1 | 44.8 | 135.7 | 313.5 |
| Eugenol | 0.4 | - | 72.9 | 122.2 |
| P-E-100 | 35.9 | 26.7 | 336.0 | 433.8 |
| P-E-50 | 23.9 | 20.10 | 308.8 | 449.0 |
| Linalool | 0.0 | - | 45.1 | 87.7 |
| P-L-100 | 0.0 | 28.0 | 244.1 | 276.7 |
| P-L-50 | 0.6 | 20.8 | 241.9 | 290.6 |
Disclaimer/Publisher’s Note: The statements, opinions and data contained in all publications are solely those of the individual author(s) and contributor(s) and not of MDPI and/or the editor(s). MDPI and/or the editor(s) disclaim responsibility for any injury to people or property resulting from any ideas, methods, instructions or products referred to in the content. |
© 2023 by the authors. Licensee MDPI, Basel, Switzerland. This article is an open access article distributed under the terms and conditions of the Creative Commons Attribution (CC BY) license (https://creativecommons.org/licenses/by/4.0/).
Share and Cite
Nowacka, M.; Kowalewska, A.; Rygala, A.; Kregiel, D.; Kaczorowski, W. Hybrid Bio-Based Silicone Coatings with Anti-adhesive Properties. Materials 2023, 16, 1381. https://doi.org/10.3390/ma16041381
Nowacka M, Kowalewska A, Rygala A, Kregiel D, Kaczorowski W. Hybrid Bio-Based Silicone Coatings with Anti-adhesive Properties. Materials. 2023; 16(4):1381. https://doi.org/10.3390/ma16041381
Chicago/Turabian StyleNowacka, Maria, Anna Kowalewska, Anna Rygala, Dorota Kregiel, and Witold Kaczorowski. 2023. "Hybrid Bio-Based Silicone Coatings with Anti-adhesive Properties" Materials 16, no. 4: 1381. https://doi.org/10.3390/ma16041381
APA StyleNowacka, M., Kowalewska, A., Rygala, A., Kregiel, D., & Kaczorowski, W. (2023). Hybrid Bio-Based Silicone Coatings with Anti-adhesive Properties. Materials, 16(4), 1381. https://doi.org/10.3390/ma16041381

